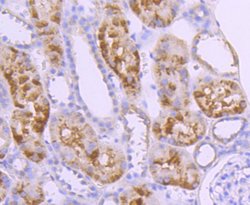
Invitrogen Caspase 10 Recombinant Rabbit Monoclonal Antibody (JJ0890) 100

Learn More
Invitrogen™ Caspase 10 Recombinant Rabbit Monoclonal Antibody (JJ0890)


Rabbit Recombinant Monoclonal Antibody
Brand: Invitrogen™ MA532459
Description
Recombinant rabbit monoclonal antibodies are produced using in vitro expression systems. The expression systems are developed by cloning in the specific antibody DNA sequences from immunoreactive rabbits. Then, individual clones are screened to select the best candidates for production. The advantages of using recombinant rabbit monoclonal antibodies include: better specificity and sensitivity, lot-to-lot consistency, animal origin-free formulations, and broader immunoreactivity to diverse targets due to larger rabbit immune repertoire.
This gene encodes a protein which is a member of the cysteine-aspartic acid protease (caspase) family. Sequential activation of caspases plays a central role in the execution-phase of cell apoptosis. Caspases exist as inactive proenzymes which undergo proteolytic processing at conserved aspartic residues to produce two subunits, large and small, that dimerize to form the active enzyme. This protein cleaves and activates caspases 3 and 7, and the protein itself is processed by caspase 8. Mutations in this gene are associated with apoptosis defects seen in type II autoimmune lymphoproliferative syndrome. Three alternatively spliced transcript variants encoding different isoforms have been described for this gene.
Specifications
| Caspase 10 | |
| Recombinant Monoclonal | |
| 1 mg/mL | |
| TBS with 0.05% BSA, 40% Glycerol and 0.05% sodium azide; pH 7.4 | |
| Q92851 | |
| CASP10 | |
| Recombinant protein within Human Caspase-10 aa 254-452. | |
| 100 μL | |
| Primary | |
| Human | |
| Antibody | |
| IgG |
| Flow Cytometry, Immunohistochemistry (Paraffin), Western Blot, Immunocytochemistry | |
| JJ0890 | |
| Unconjugated | |
| CASP10 | |
| ALPS2; Apoptotic protease Mch-4; CASP10; CASP-10; caspase 10; caspase 10 apoptosis-related cysteine peptidase; caspase 10, apoptosis-related cysteine peptidase; caspase 10, apoptosis-related cysteine protease; caspase-10; Caspase-10 subunit p12; Caspase-10 subunit p23/17; FADD-like ICE2; FAS-associated death domain protein interleukin-1B-converting enzyme 2; FLICE2; ICE-like apoptotic protease 4; interleukin-1B-converting enzyme 2; MCH4 | |
| Rabbit | |
| Protein A | |
| RUO | |
| 843 | |
| Store at 4°C short term. For long term storage, store at -20°C, avoiding freeze/thaw cycles. | |
| Liquid |
Your input is important to us. Please complete this form to provide feedback related to the content on this product.